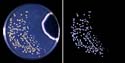

about | articles | authors | contact | links
 about | articles | authors | contact | links |
![]() Home > Articles > Fluorescence Photography > Applications of the ultraviolet technique
Home > Articles > Fluorescence Photography > Applications of the ultraviolet technique
FLUORESCENCE PHOTOGRAPHYAuthors: Prof. Robin Williams and Gigi Williams Applications of the ultraviolet technique:
|
 Figure 11. Fluorescence of tinea capitas. |
Figure 12. Fluorescence of H. Pertussis. |
 Figure 13. Bacterial invasion of epidermoid carcinoma. |
 Figure 14. Plasma from Porphyria patient. |
 Figure 15. Tetracycline uptake. |
 Figure 16. Callosites of the skin. |
 Figure 17. Fluorescence of wood. |
 Figure 18. Fluorescence of bone fragments. |
 Figure 19. Shroud of Turin. |
 Figure 20. Analysis of the Shroud of Turin. |
 Figure 21. Fluorescence of plasma. |
 Figure 22. Plasma on a porous substrate. |
 Figure 23. Alteration to a document. |
 Figure 24. Fluorescnece of calcite. |
 Figure 25. Composite sample of calcite and willemite. |
 Figure 26. Chromatography. |
 Figure 27. Soaps, cleansers and cosmetics. |
 Figure 28. Rhipicephalus appendiculatus. |
 Figure 29. Detection of cracks. |
 Figure 30. Head of a femur. |
Figure 31. Distinguishing between RNA and DNA. |
 Figure 32. Cyanoacrylate fixed fingerprint with Ninhydrin. |
 Figure 33. Cyanoacrylate fixed fingerprint with Rodamine 6G. |
| © 2002 Prof. Robin Williams and Gigi Williams - Disclaimer URL: http://www.medicalphotography.com.au/Article_02/ Last modified: 3 May 2002 |